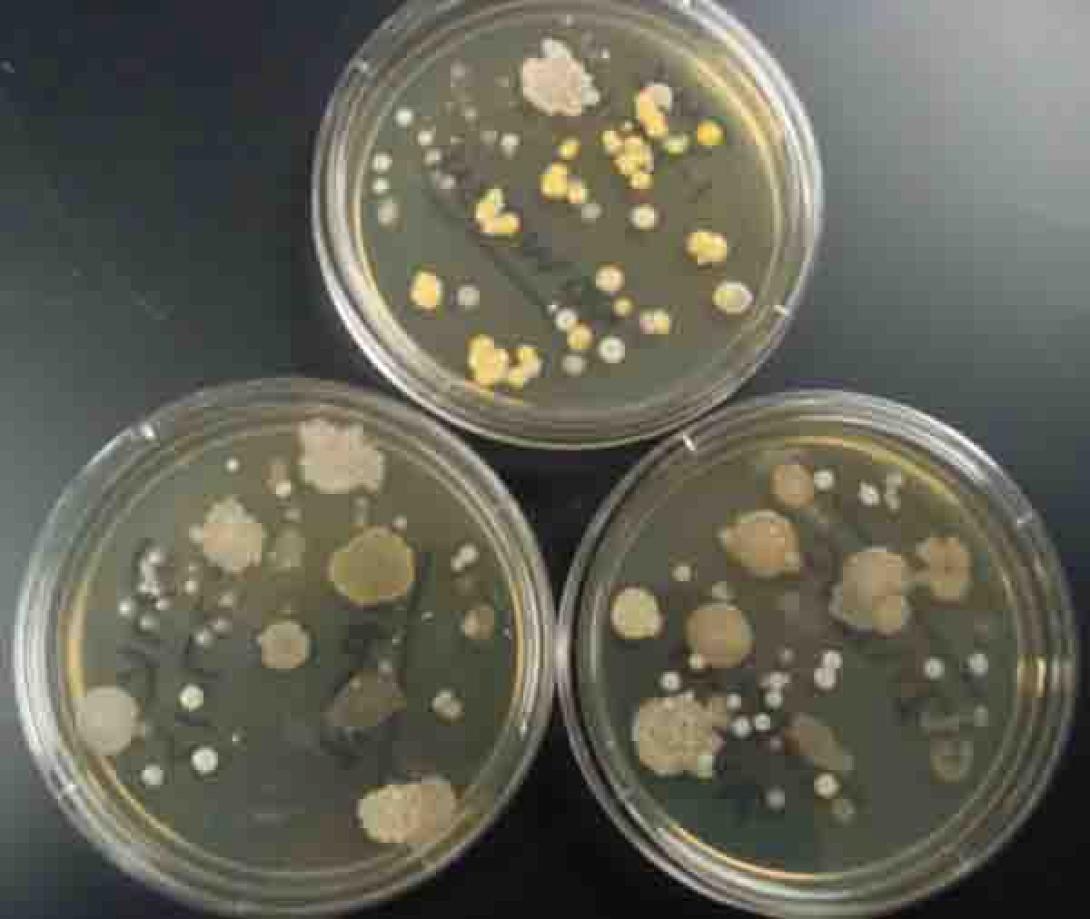
touch-plates-far-sil.jpg

Το DNA των μικροβίων που ζουν στο ανθρώπινο σώμα μπορεί να χρησιμοποιηθεί για να ταυτοποιηθεί ένας άνθρωπος, κάτι που είναι πιθανό να αξιοποιήσει η εγκληματολογική έρευνα στο μέλλον.
Η νέα τεχνική -που βρίσκεται υπό τελειοποίηση- αναλύει το συνολικό γενετικό υλικό των μικροβίων που «συζούν» με τους ανθρώπους και όχι το DNA των ίδιων των ανθρώπων.
Ουσιαστικά, είναι η πρώτη φορά που μια μελέτη δείχνει ότι είναι εφικτό να γίνει ταυτοποίηση κάποιου ανθρώπου από το μικροβιακό «αποτύπωμά» του. Δεν θα υπάρχει έτσι πλέον η ανάγκη για ανάλυση του ίδιου του ανθρώπινου DNA, όπως γίνεται εδώ και δεκαετίες.
Τα παραδοσιακά δαχτυλικά αποτυπώματα φαντάζουν πια όλο και πιο ξεπερασμένα, καθώς οι επιστήμονες ανακαλύπτουν συνεχώς νέους τρόπους βιολογικής ταυτοποίησης ενός ανθρώπου. Ερευνητές στις ΗΠΑ ανακοίνωσαν ότι, χάρη σε ένα νέο αλγόριθμο υπολογιστή, μπορούν να «διαβάσουν» με αρκετή ακρίβεια τη μοναδική μικροβιακή «υπογραφή» κάθε ανθρώπου.
Η νέα τεχνική βασίζεται στο γεγονός ότι κάθε άνθρωπος φέρει πάνω και μέσα στο σώμα του ένα πλούσιο αλλά μοναδικό μικροβίωμα, δηλαδή ένα «οικοσύστημα» βακτηριακών κοινοτήτων. Με άλλα λόγια, ‘δείξε μου τα βακτήριά σου, να σου πώς ποιός είσαι'.
Οι ερευνητές της Σχολής Δημόσιας Υγείας του Πανεπιστημίου Χάρβαρντ, που έκαναν τη σχετική δημοσίευση στο περιοδικό «Πρακτικά της Εθνικής Ακαδημίας Επιστημών» (PNAS) των ΗΠΑ, χρησιμοποίησαν δείγματα μικροβίων που είχαν ληφθεί (από σάλιο, δέρμα, κόπρανα, κόλπο κ.α.) από 242 άτομα, στο πλαίσιο του Προγράμματος Ανθρωπίνου Μικροβίωματος, όπως μετέδωσε το Αθηναϊκό Πρακτορείο.
Με τη βοήθεια του ειδικού λογισμικού, οι επιστήμονες διαπίστωσαν ότι, παρόλο που το μικροβίωμα διαχρονικά εμφανίζει αλλαγές, ανάλογα με τη διατροφή, το περιβάλλον, την υγεία κλπ. του ανθρώπου, παράλληλα έχει και μια σταθερή πλευρά σε βάθος χρόνου.
Οι δοκιμές έδειξαν ότι, αναλύοντας δείγματα μικροβίων από το έντερο, οι ερευνητές μπόρεσαν να ταυτοποιήσουν έως το 86% των ανθρώπων, των οποίων είχαν ληφθεί μικροβιακά δείγματα πριν από ένα έτος. Από όλα τα δείγματα βιολογικού υλικού, η καλύτερη ταυτοποίηση γίνεται μέσω της ανάλυσης των κοπράνων, ενώ η λιγότερο ακριβής μέσω του δέρματος.
Οι επιστήμονες αναγνώρισαν ότι η νέα μέθοδος -που είναι υπό τελειοποίηση- μπορεί να εγείρει νέες ανησυχίες, όσον αφορά την προστασία των ιδιωτικών δεδομένων. Ήδη υπάρχουν ενστάσεις για την ταυτοποίηση ατόμων μέσω του ανθρώπινου γενετικού υλικού (DNA) τους.
Όσον αφορά στο ζήτημα της ιδιωτικότητας, είναι πιθανό να υπάρξουν αντιδράσεις στο μέλλον και για τη νέα μέθοδο ταυτοποίησης, ιδίως στο βαθμό που αρχίσουν να δημιουργούνται νέες βάσεις γενετικών δεδομένων με το διακριτό μιοκροβιακό DNA κάθε ανθρώπου.
Μεταξύ άλλων, το μικροβιακό DNA ενός ανθρώπου θα μπορούσε να αποκαλύψει -χωρίς τη συγκατάθεσή του- σεξουαλικά μεταδιδόμενες και άλλες ασθένειες, παραβιάζοντας έτσι το ιατρικό απόρρητο.